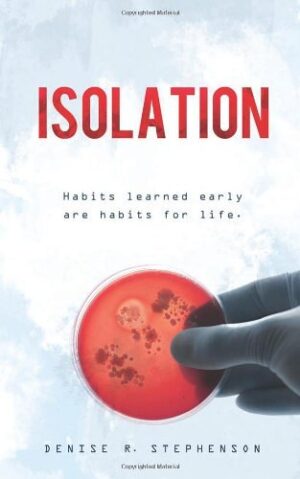

Isolation depicts a bleak but recognizable future in which the fear of contagion reaches a fever pitch as a bacterial epidemic catapults the US into an apocalyptic crisis. Touch is outlawed. Mothers like Maggie bind their infants’ hands, terrified they might slip fingers into mouths. Gary, a Sterilizer, uses robots to scour the infected, avoiding all contact with human flesh. Trevor, the Chief Enforcer, watches, eager to report any and all infractions. One inadvertent touch will change all of their lives.
No more offers for this product!
General Inquiries
There are no inquiries yet.